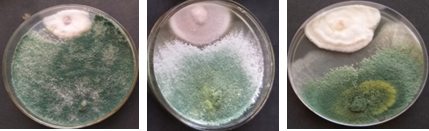

Crop Protection Technologies
DALHANDERMA
| S. No. | Title | Protection Technology 2 |
|---|---|---|
| 1 (a) | Name of Division: | Division of Crop Protection |
| (b) | Name of Institute: | ICAR-Indian Institute of Pulses Research, Kanpur |
| 2. | Title of the Research & Technologies developed during the last year five years: | DALHANDERMA (IIPRTh-31)
|
| 3. | Salient feature of the Research/Technology : | (i) DALHANDERMA is a talc based formulation of potential Trichoderma asperallum strain (IIPRTh-31) registerd with ICAR-NBAIM, Mau (Reg. No. NAIMCC-R-5) for further commercialization at farmer fields as seed treatment @ 10gm/kg of seed for soilborne diseases management and plant growth promotion in major pulses.
(ii) DALHANDERMA given to ICAR-Agri Innovate for commercialization in the last year July, 2022. (iii) The main objective to develop a multi-trait biocontrol formulation effective for management of soilborne and root rot diseases of pulse crops and enhancing their plant growth. (iv) Developed formulation were improving the soil fertility and increasing microbial population in soil ultimate enhancing crop yield (up to 10-12%) also. (v) Significant increases in seed germination, Shoot length, root length plant height and recorded maximum grain yield in Pigeonpea, Chickpea and Lentil over check. |
| 4. | Developed by (Name/Designation/Contact no./Email Id): | Lead: R.K.Mishra
Associate: Naimuddin, Sonika Pandey, Monika Mishra, PR Saabale, RG Chaudhary, Bansa Singh, NP Singh, GP Dixit Contact: Director, ICAR-IIPR, Kanpur |
| 5. | How this Technology contributed to agricultural advancements or improved farmer practices : | · Institute level: Developed formulation have been evaluated in major pulse crops at ICAR-IIPR Regional Stations, Bhopal, Kanpur, Dharwad, Bikaner during 2020-21, 2021-22.
· Collaborators: Tested at farmers fields in chickpea, pigeonpea and lentil crop during 2019-20, 2020-21, 2021-22 & 2022-23 under different externally funded projects (UPCST, UPCAR, IITM, FARMER FIRST) with collaboration of KVKs. · Multi-location: testing in AICRP (Pigeonpea and Chickpea) in different centres during 2022-23 crop season. |
| 6. | Details of Impact on farmer’s livelihood and agricultural practices: | · Generated in-vitro research data and shelf life evaluation of developed formulation.
· In vitro antagonistic results showed that IPRTh-31 showed high antagonistic activity against F. oxysporum f. sp. lentis (Fol) (83.75%), F. oxysporum f. sp. ciceri (Foc) (82.3%) and Fusarium udum (Fu) (80.6%). Shelf life of developed formulation was maintained up to 7.7×106 for 14 months. · Potential stains and their developed formulation were extensively tested under green house for wilt disease suppression and plant growth promotion potential in major pulse crops. · Green house experiments showed up to 60% increase in plant growth over control and 55% of wilt disease resistance. |
| 7. | Any other Information: | · Characterization of mycolytic gene (ech-42 & Xyn-2: and whole genome were also done and submitted to NCBI data base.
· Pure culture has been submitted to ICAR-NBAIM, Mau also and submitted to ICAR-Agri Innovate |
DALHANDERMA-1(Pulse Booster)
| S. No. | Title | Protection Technology 2 |
|---|---|---|
| 1 (a) | Name of Division: | Division of Crop Protection |
| (b) | Name of Institute: | ICAR-Indian Institute of Pulses Research, Kanpur |
| 2. | Title of the Research & Technologies developed during the last year five years: | DALHANDERMA-1 (IIPRTh-33)
|
| 3. | Salient feature of the Research/Technology : | (vi) DALHANDERMA-1 (Pulse Booster) is a talc based formulation of potential Trichoderma afroharzianum strain (IIPRTh-33) registerd with ICAR-NBAIM, Mau (Reg. No. NAIMCC-R-6) for further commercialization at farmer fields as seed treatment @ 10gm/kg of seed for soilborne diseases management and plant growth promotion in major pulses.
(vii) DALHANDERMA-1(Pulse Booster) given to ICAR-Agri Innovate for further commercialization in the last year July, 2022. |
| 4. | Developed by (Name/Designation/Contact no./Email Id): | Lead: R.K.Mishra
Associate: Naimuddin, Sonika Pandey, Monika Mishra, Uma Sah, Krishna Kumar, NP Singh, GP Dixit Contact: Director, ICAR-IIPR, Kanpur |
| 5. | How this Technology contributed to agricultural advancements or improved farmer practices : | · Institute level: Developed formulation have been evaluated in major pulse crops at ICAR-IIPR Regional Stations, Bhopal, Kanpur, Dharwad, Bikaner during 2020-21, 2021-22.
· Collaborators: Tested at farmers fields in chickpea, pigeonpea and lentil crop during 2019-20, 2020-21, 2021-22 & 2022-23 under different externally funded projects (UPCST, UPCAR, IITM, FARMER FIRST) with collaboration of KVKs. · Multi-location: testing in AICRP (Pigeonpea and Chickpea) in different centres during 2022-23 crop season. |
| 6. | Details of Impact on farmer’s livelihood and agricultural practices: | · The main objective to develop a multi-trait biocontrol formulation effective for management of soilborne and root rot diseases of pulse crops and enhancing their plant growth.
· The proposed formulation was tested under different agro climatic zones against wilt and root rot in chickpea, pigeon pea and lentil. The proposed product showed 30-35% increase in plant growth and up to 30% increase in disease resistance. · The amount of biocontrol agents required to supply plants with the same amount of nutrients is much less than chemical fertilizers. Additionally, this low-cost method of supplying nutrients to soil makes it attractive to small-holder farmers. · Developed formulation settle down in the rhizosphere region and enhance soil productivity and solubilizing different nutrients, thereby exerting direct or indirect beneficial effects on crop growth and yield through different defense mechanisms. · Proposed formulation is effective against a variety of pathogens and able to maintain the soil fertility under different agro-climatic conditions. · Proposed formulation has efficiency to work against soil borne as well as seed borne pathogens. · Proposed product is cost effective as the market value of this product is very low as compared to the chemical fertilizers and it does not leave any harmful effects on the environment. · Proposed formulation is unique as it shows promising results against phytopathogens. · Shelf Life of developed formulation up to 14 months was 5.2×106. |
| 7. | Any other Information: | · Characterization of mycolytic gene (ech-42 & Xyn-2:
· Whole genome were also done and submitted to NCBI data base. Pure culture has been deposited to ICAR-NBAIM, Mau · Submitted to ICAR-Agri Innovate for commercialization |